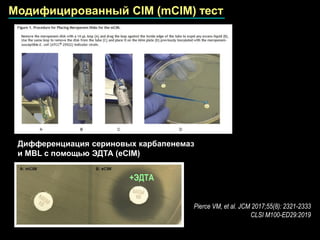

Имипенем Эдта

💣 👉🏻👉🏻👉🏻 ИНФОРМАЦИЯ ДОСТУПНА ЗДЕСЬ! КЛИКАЙ 👈🏻👈🏻👈🏻
Имипенем + Эдта Imi+Ed
Имипенем с ЭДТА и без ЭДТА — инструкция по применению . . .
Диски с имипенемом + ЭДТА, 10 мкг
Имипенем-ЭДТА 10/750 мкг (1уп .=10карт .х50дисков) (ФСЗ 2012 . . .
Упаковки препарата Имипенем-ЭДТА (для бактериологии . . .
HiMedia SD282-10СT Имипенем-ЭДТА 10/750 мкг, 10карт . . .
Упаковки препарата Имипенем с ЭДТА и без ЭДТА — дозировка . . .
Диски с Имипенем + ЭДТА, 292 мкг
Описание ИМИПЕНЕМ показания, дозировки, противопоказания . . .
ИМИПЕНЕМ фл . 500 мг . / 500 мг . 20 мл . * 5 (IMIPENEM fl . . .
Анаприлин И Валосердин
Зенон Блоки Питания
После Компресса С Димексидом
Имипенем + ЭДТА imi+ed в интернет-каталоге МИКРО-ЛАБ . Гарантия качества от производителя . Доставка по России .
Имипенем с ЭДТА и без ЭДТА: инструкция, характеристика, действие на организм, свойства . . .
Имипенем+ЭДТА 10 .Реагенты in vitro на дисках для определения чувствительности микроорганизмов . . .
Имипенем-ЭДТА 10/750 мкг (1уп .=10карт .х50дисков) (ФСЗ 2012/12473) - купить в Екатеринбурге . Мы работаем с 2003 года . Проверено временем . info@art-medika .com . +7(343)287-97-41 . +7(343) 213-52-79 . +7(343) 213-52-80 . Поиск: . Корзина .
Упаковки препарата Имипенем-ЭДТА (для бактериологии) — дозировка, форма выпуска, описание лекформы, штрихкод, номер РУ
SD282-10СT Имипенем-ЭДТА (10/750 мкг, 10карт .х50дисков) ФСЗ 2009/03589 Упаковка Imipenem/EDTA (IE) 10/ 750 мкг включает 10 картриджей по 50 шт . дисков и один диспенсер на один картридж
Упаковки препарата Имипенем с ЭДТА и без ЭДТА — дозировка, форма выпуска, описание лекформы, штрихкод, номер РУ
Имипенем+ЭДТА 292 .Реагенты in vitro на дисках для определения чувствительности . . .
Фармакологическое действие . Антибиотик группы карбапенемов широкого спектра действия . Оказывает бактерицидное действие за счет ингибирования клеточной стенки бактерий . Активен в отношении аэробных грамположительных бактерий: Staphylococcus spp . (в т .ч . штаммы, продуцирующие . . .
ИМИПЕНЕМ фл . 500 мг . / 500 мг . 20 мл . * 5 (IMIPENEM fl . 500 mg . / 500 mg . 20 ml . * 5), цена и информация . ИМИПЕНЕМ фл . 500 мг . / 500 мг . 20 мл . * 5 е медикамент от Лекарствени продукти отпускащи се по лекарско предписание - актуална цена и листовка . Продукт произведен от . 0 . В целия сайт .
Деринат Для Профилактики Форум
Эдарби 98 Штук
Фенилэфрин 4 Раза В Год
Розувастатин 10 Отзывы Пациентов
Чем Разбавляют Диоксидин В Нос
Аптека Эвалар Отзывы
Мукалтин Таблетки Ребенку 6 Лет
Сотри Номер Бывшего
Левосин Аналоги По Действующему Веществу
Сравнить Спермактин Форте И Сперотон
Мексидол Или Нейромидин Что Лучше
Метионин Для Кожи Лица
Бимикомби Антиглау Эко Отзывы
Хелидониум Композитум Инструкция
Акаки И Фиксай В Мире Эйсипи
Макмирор Цена Калининград
Престанс Кто Выпускает
Ко Дальнева Отзывы Врачей Кардиологов И Пациентов
Отривин Спрей Назальный Инструкция
Линкас Орви
Фукорцин Слизистая
Ксарелто При Ковиде
Лонгидаза Чем Растворять Уколы
Доктор Мом Леденцы Детям Можно
Тримедат Или Тримедат Форте В Чем Разница
Сколько Колоть Дексаметазона Коту
Глюкозамин Ультра Мсм 1500 300
Элеутерококка Экстракт Аптека
Витапрост Таб
Эспумизан Способ Применения Новорожденному
Найз Сироп
Сироп Джосет Цена Минск
Для Чего Нужна Серная Мазь
Унитиол Рлс
Салофальк Свечи Фото
Инструкция По Применению Ярины
Эксхол 250 Цена Суспензия
Сколько Стоит Эссенциале Форте М
Ницерголин 30
Трависил Леденцы Инструкция По Применению Цена
Глево Левофлоксацин Что Лучше
Нитроспрей Показания
Негативные Реакции Рибоксин Возникают
Фурацилин Щелочь
Предуктал Mr Цена В Москве
Виброцил Масляные Капли
Радевит Инструкция По Применению Цена Отзывы Аналоги
Корвалол И Корвалол Фито В Чем Разница
Називин Спрей Взрослый Цена Отзывы
Гидрокарбонат Натрия Выделение Газа
Таблетки Доппельгерц
Одестон И Урдокса
Ивепред 1000 Мг Для Капельницы
Аденопросин Или Уропрост
Структум Таблетка Бай Могилев
Трава Эрвы Куплю
Отипакс Или Дроплекс
Победим Вместе Саксенда Аптеки
Суперлимф Отзывы Форум
Буденит Стери Неб Для Ингаляций 0.25
Фенхель Обыкновенный Применение
Омез Для Собак
Риностоп Показания
Вольтарен Инъекции Цена Москва
Макмирор Мазь Для Мужчин Как Применять
Курантил Аритмия
Тербинафин Таблетки Импортные
Леркамен И Периндоприл Совместимость
Ингавирин 90 Цена Ярославль
Противопоказания Янтарной Кислоты Таблеток
Помогает Ли Но Шпа От Вздутия
Тержинан Свечи После Применения
Триган Д У Подростков
Циклоферон 2.0 Уколы
Карсил К Какой Группе Препаратов Относится
Альгинат Кальция Арго Применение
Сколько Стоит Слабилен В Каплях
Сомниум Революция
Клексан Одинцово
Таблетки Для Суставов Терафлекс Здоров Ру
Энтеросгель При Поносе У Ребенка
Рисперидон Вес Не Набирается
Аптека Новинет
Тенорик 100 Мг Инструкция
Что Лучше Арбидол Или Умифеновир Отзывы
Энтекавир Сандоз Отзывы Больных Гепатитом Б
Надо Ли Запивать Феназепам Водой
Эссенциале Цена Брест
Гидроксихлорохин Схема
Флуифорт Цена В Уфе
Паста Для Детей С Кальцием
Таблетки Клайра Цена
Кеппра В Росси Поставки
Нейромидин 1 Мл 10 Ампулы
Прогинова Цена Омск
Постинор Барановичи
Флоресан Сжигатель Жира Отзывы
Канефрон Н Действие
Доза Приема Метронидазол
Софрадекс Действующее Вещество
Имипенем Эдта